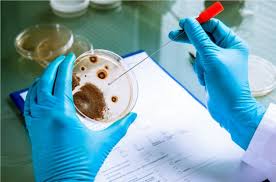
soil and water testing laboratories in 57 schools and colleges. | ५७ विद्यालये, महाविद्यालयांमध्ये लघू माती व पाणी परीक्षण प्रयोगशाळा होणार! soil and water testing laboratories in 57 schools and colleges. | ५७ विद्यालये, महाविद्यालयांमध्ये लघू माती व पाणी परीक्षण प्रयोगशाळा होणार!

५७ विद्यालये, महाविद्यालयांमध्ये लघू माती व पाणी परीक्षण प्रयोगशाळा होणार!
By लोकमत न्यूज नेटवर्क | Updated: December 4, 2018 12:18 IST2018-12-04T12:16:58+5:302018-12-04T12:18:06+5:30
अकोला: पंतप्रधान नरेंद्र मोदी यांच्या संकल्पनेनुसार संत गाडगेबाबा अमरावती विद्यापीठाच्या निरंतर शिक्षण व विस्तार विभागाद्वारे विद्यालये आणि महाविद्यालयांमध्ये लघू माती व पाणी प्रयोगशाळांचा एक नावीन्यपूर्ण पथदर्शी प्रकल्प राबविण्यात येणार आहे.
५७ विद्यालये, महाविद्यालयांमध्ये लघू माती व पाणी परीक्षण प्रयोगशाळा होणार!
अकोला: पंतप्रधान नरेंद्र मोदी यांच्या संकल्पनेनुसार संत गाडगेबाबा अमरावती विद्यापीठाच्या निरंतर शिक्षण व विस्तार विभागाद्वारे विद्यालये आणि महाविद्यालयांमध्ये लघू माती व पाणी प्रयोगशाळांचा एक नावीन्यपूर्ण पथदर्शी प्रकल्प राबविण्यात येणार आहे. अकोला जिल्ह्यातील ५७ विद्यालये, महाविद्यालयांमध्ये हा उपक्रम राबविल्यानंतर आता पातूर तालुक्यात मानव विकास कार्यक्रमांतर्गत लघू माती व पाणी परीक्षण प्रयोगशाळा सुरू करण्याचे प्रयत्न सुरू आहे.
शेतकऱ्यांच्या कल्याणासाठी, कौशल्यवृद्धी आणि उत्पादकता वाढीच्या दृष्टिकोनातून मानव विकास कार्यक्रमांतर्गत पातूर तालुक्यात अनुदानित विद्यालये, कनिष्ठ महविद्यालये लघू माती व पाणी प्रयोगशाळा प्रशिक्षणासह स्थापन करण्यात येणार आहेत. संत गाडगेबाबा अमरावती विद्यापीठाच्या निरंतर शिक्षण व विस्तार विभागाद्वारे जिल्ह्यातील ५७ विद्यालये आणि महाविद्यालयांमध्ये लघू माती व पाणी परीक्षण प्रयोगशाळा स्थापन करण्यात आल्या. हाच प्रकल्प मानव विकास कार्यक्रमांतर्गत पातूर तालुक्यात राबविण्याचा विद्यापीठाचा प्रयत्न सुरू आहे. त्यासाठी लागणाºया निधीची संत गाडगेबाबा विद्यापीठ अमरावतीने जिल्हाधिकाºयांना ५१ लाख रुपयांच्या निधीची मागणी केली होती. त्यानुसार शासनाने पातूर तालुक्याची आर्थिक मर्यादा विचारात घेऊन २६.८८ लाख रुपयांच्या निधीस मंजुरी दिली आहे. तालुक्यातील २१ विद्यालये, महाविद्यालयांमध्ये लघू माती व पाणी परीक्षण प्रयोगशाळा सुरू करण्याचे काम सुरू झाले आहे. तालुक्यातील शेतकºयांना माती व पाणी याबाबत योग्य माहिती मिळावी आणि उत्पादनात वाढ व्हावी, या उद्देशाने हा उपक्रम राबविण्यात येणार आहे. (प्रतिनिधी)